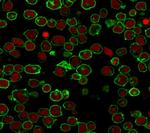
CD45/LCA (B-Cell Marker) Antibody in Immunocytochemistry (ICC/IF)

Search
NeoBiotechnologies
CD45/LCA (B-Cell Marker) Monoclonal Antibody (PTPRC/1461)
{{$productOrderCtrl.translations['antibody.pdp.commerceCard.promotion.promotions']}}
{{$productOrderCtrl.translations['antibody.pdp.commerceCard.promotion.viewpromo']}}
{{$productOrderCtrl.translations['antibody.pdp.commerceCard.promotion.promocode']}}: {{promo.promoCode}} {{promo.promoTitle}} {{promo.promoDescription}}. {{$productOrderCtrl.translations['antibody.pdp.commerceCard.promotion.learnmore']}}
产品信息
5788-MSM21-P0
种属反应
宿主/亚型
分类
类型
克隆号
抗原
偶联物
形式
浓度
纯化类型
保存液
内含物
保存条件
运输条件
靶标信息
CD45 (LCA, leukocyte common antigen) is a receptor-type protein tyrosine phosphatase (PTP) ubiquitously expressed in all nucleated hematopoietic cells, comprising approximately 10% of all surface proteins in lymphocytes. CD45 is absent on non-hematopoietic cell lines, normal and malignant, non-hematopoietic tissues. CD45 glycoprotein is crucial in lymphocyte development and antigen signaling, serving as an important regulator of Src-family kinases. CD45 protein exists as multiple isoforms as a result of alternative splicing, differ in their extracellular domains but share identical transmembrane and cytoplasmic domains. CD45RA is an isoform of the CD45 complex and has restricted expression between different subtypes of lymphoid cells. CD45 isoforms differ in their ability to translocate into the glycosphingolipid-enriched membrane domains and their expression depends on cell type and physiological state of the cell. CD45 has been shown to be an essential regulator of T- and B-cell antigen receptor signaling and suppresses JAK kinases to regulate cytokine receptor signaling. CD45 is also important in promoting cell survival by modulating integrin-mediated signal transduction pathway, DNA fragmentation during apoptosis and inhibition or upregulation of various immunological functions.
仅用于科研。不用于诊断过程。未经明确授权不得转售。
篇参考文献 (0)
生物信息学
蛋白别名: CD45; CD45 antigen; L-CA; Leukocyte common antigen; protein tyrosine phosphatase, receptor type, C; protein tyrosine phosphatase, receptor type, c polypeptide; Receptor-type tyrosine-protein phosphatase C; T200; T200 glycoprotein; T200 leukocyte common antigen; T220 and B220
基因别名: B220; CD45; CD45R; GP180; L-CA; LCA; LY5; PTPRC; T200
UniProt ID: (Human) P08575
Entrez Gene ID: (Human) 5788